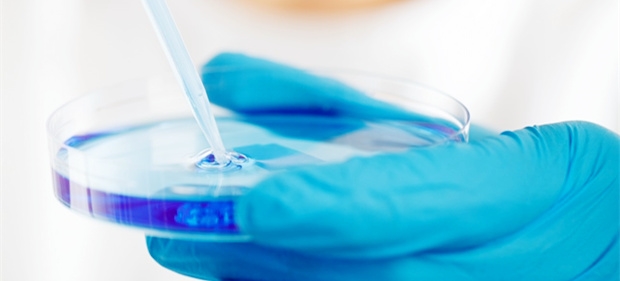

Phytonutrient Application
One of the biggest hidden treasures of the mother nature is the undiscovered functions & properties of natural plants, floral & fauna. Many of the biggest medical discoveries are derived from natural plants. One of our main objectives is to discover the greatest natural health treasure that would revolutionize mankind's health!
Scientists estimate that there are about 10,000 different phytochemicals that are considered beneficial in the prevention of chronic diseases such as cancer, stroke, and heart disease. Although certain phytochemicals are available as dietary supplements, research suggests that their health benefits are best obtained through quality raw materials & ingredients.
Laboratory studies prove that phytochemicals in fruits and vegetables may reduce the risk of cancer, partially due to dietary fibers, polyphenol antioxidants and anti-inflammatory effects.